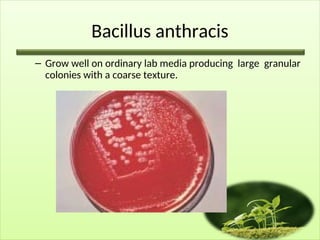
Bacillus anthracis
– Grow well on ordinary lab media producing large granular
colonies with a coarse texture.

Bacillus anthracis, a large gram-positive aerobic bacilli, is the primary pathogen in the Bacillus group and is known for causing anthrax, primarily affecting animals but can also infect humans through skin contact, inhalation, or ingestion of spores. The bacteria possess virulence factors such as a capsule that helps resist phagocytosis and a complex exotoxin produced in animal tissues. Diagnosis involves specific laboratory tests and treatment typically includes antibiotics like penicillin or tetracycline, with a vaccine available for high-risk individuals.